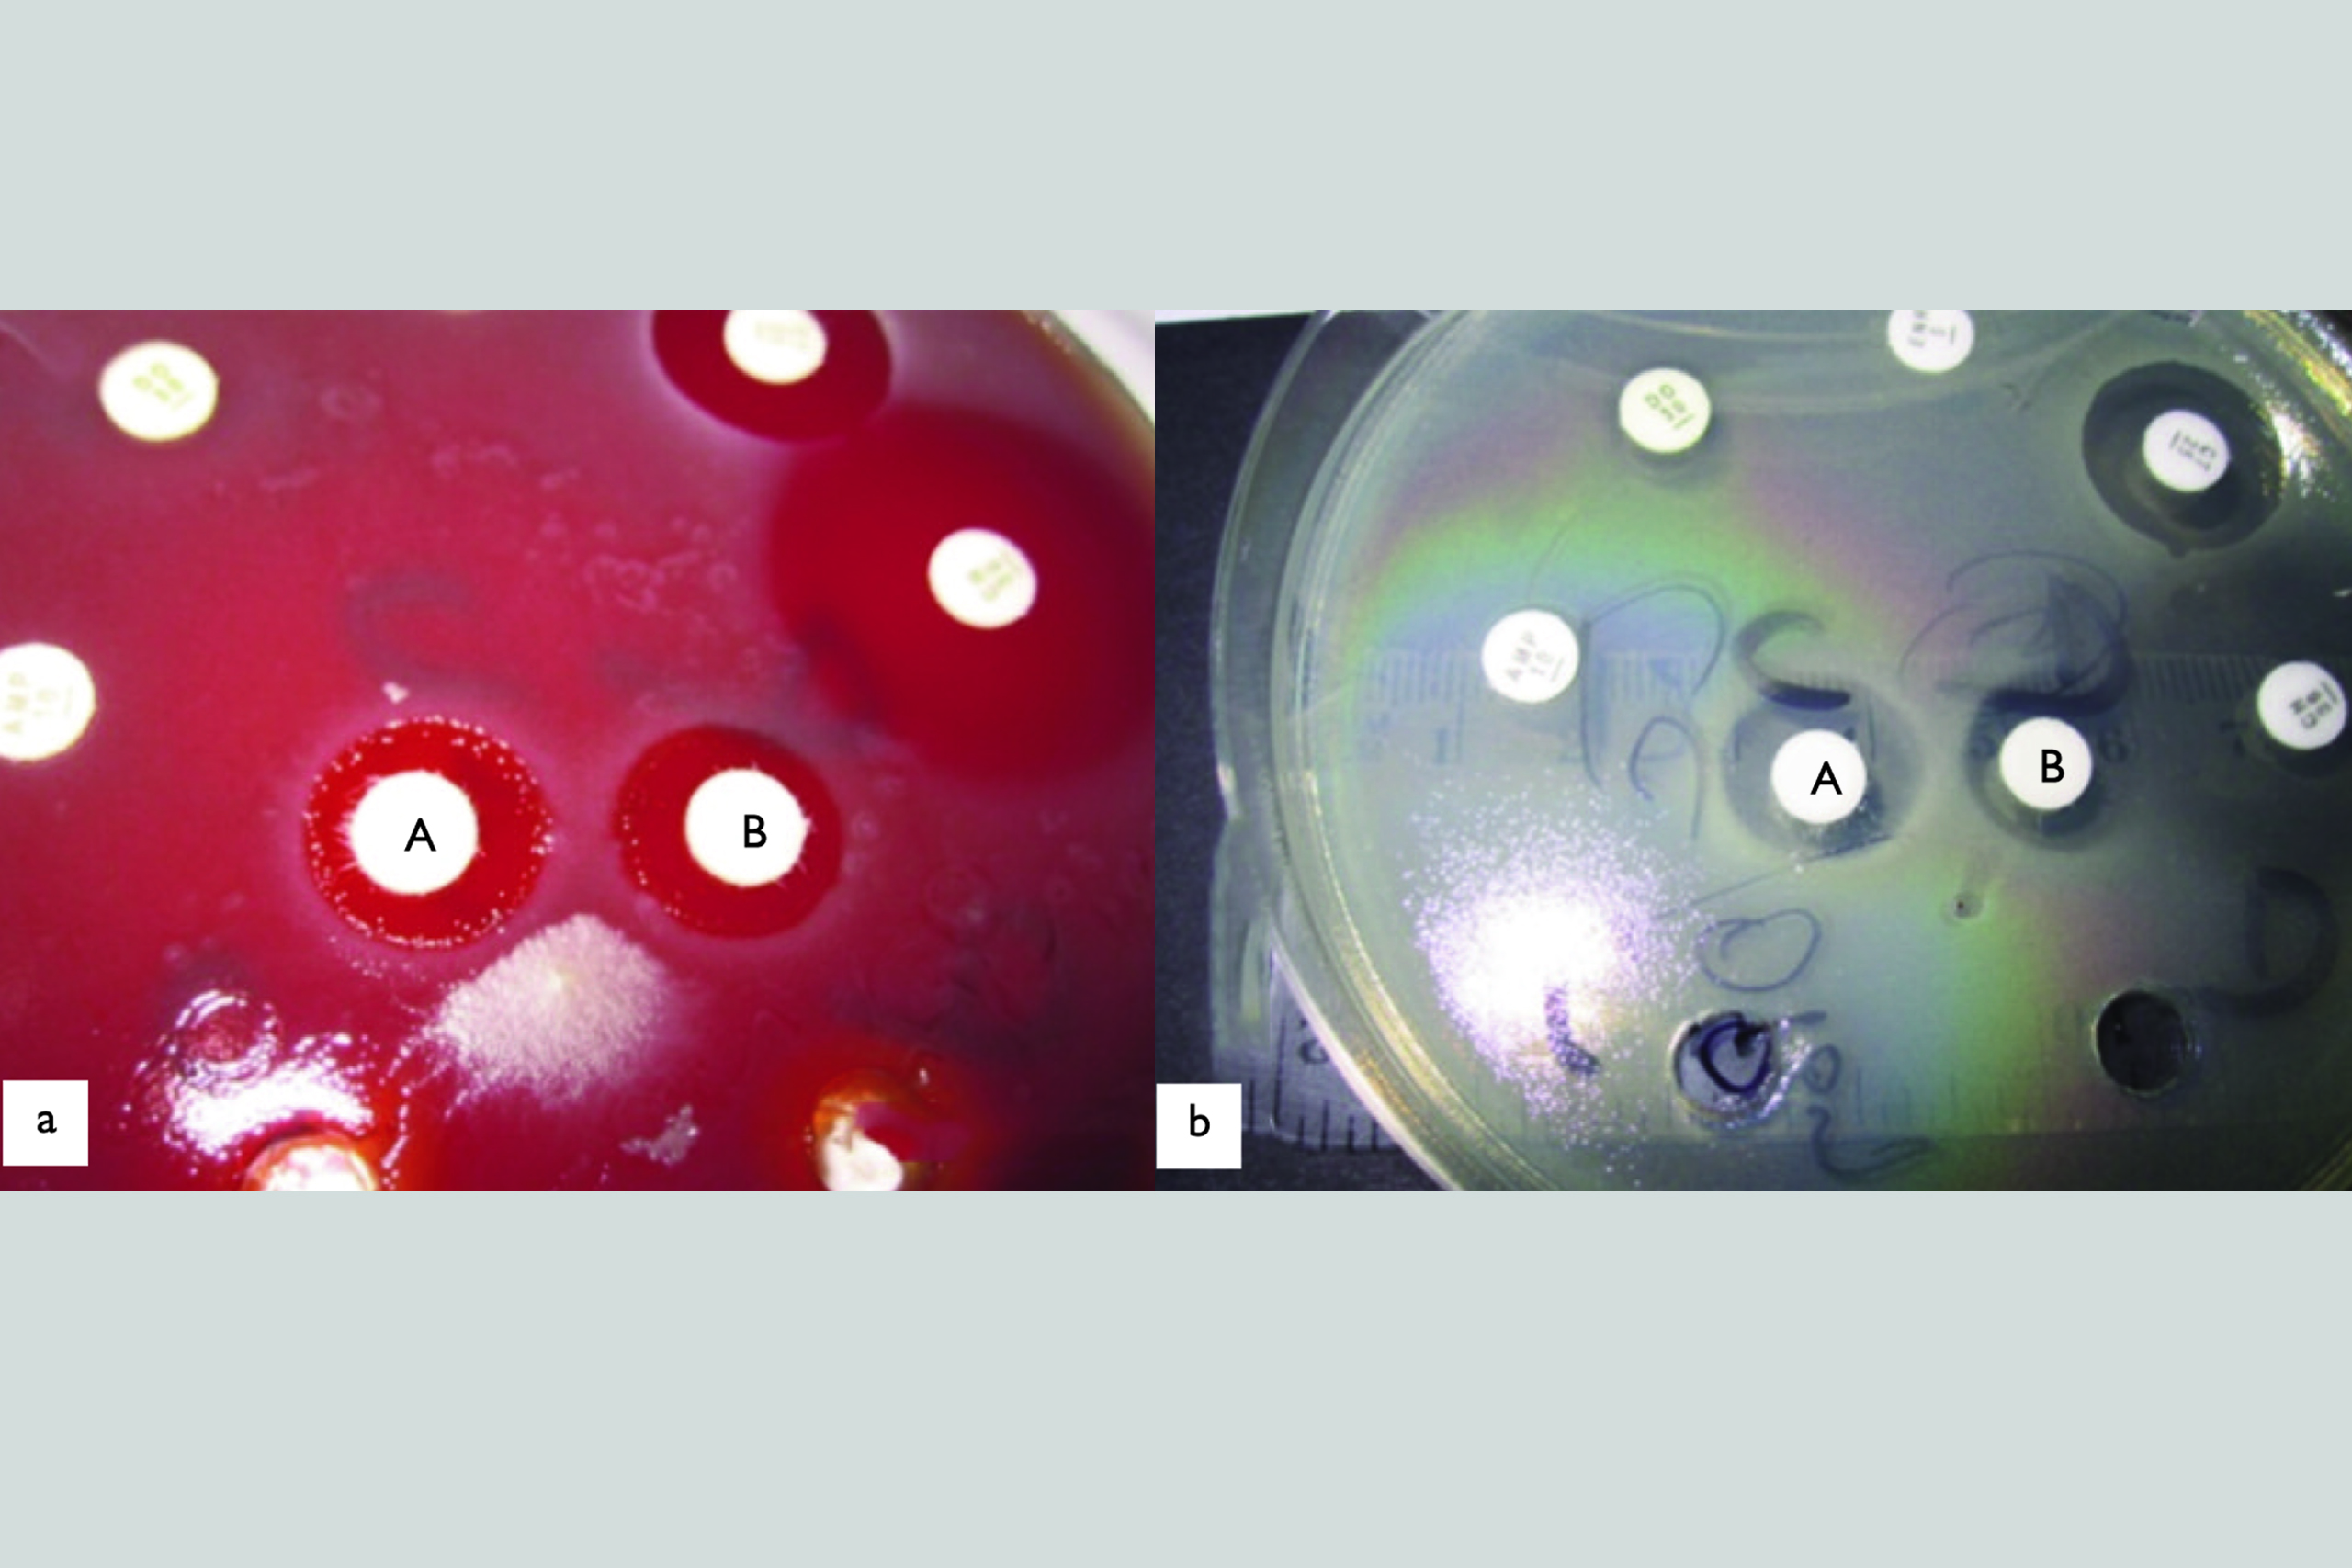
Respiratory3

Articles / Films
Treating respiratory tract infections in poultry with the use of herbs
The article discusses respiratory health issues in poultry caused by poor farming conditions, such as inadequate ventilation, high humidity, excessive dust, poor-quality bedding, and high concentrations of harmful gases. It emphasizes that the unique structure of the avian respiratory system makes birds particularly susceptible to bacterial, viral, and fungal infections.
Main threats to the respiratory system in poultry:
- Overheating – High temperatures lead to dehydration of the mucous membranes, increasing vulnerability to infections. Symptoms include reduced appetite, rapid breathing, excessive water consumption, and wing flapping.
- Underheating – Particularly dangerous for young birds with underdeveloped thermoregulation, leading to weakened immunity and susceptibility to infections (E. coli, Mycoplasma, Aspergillus sp.).
- Poor bedding quality – Serves as a breeding ground for bacteria and fungi, causing respiratory problems such as wheezing, sneezing, and characteristic “yawning.”
- Excessive dust – Fine airborne particles damage the respiratory tract, leading to symptoms like wheezing and breathing difficulties.
- Harmful gases – Excess ammonia and hydrogen sulfide irritate mucous membranes and damage protective cilia, leading to inflammation and respiratory distress.
Natural methods to support the respiratory system:
The article suggests alternative methods for maintaining poultry respiratory health, including natural plant-based substances:
- Mint oil (menthol) – Acts as an expectorant, antibacterial agent, cooling agent, and disinfectant.
- Eucalyptus oil – Relaxes respiratory muscles, clears airways, and improves lung ventilation.
- Vitamin A – Strengthens immunity, protects mucous membranes from drying out, and supports cell regeneration.
- Garlic (allicin) – Has strong antibacterial properties, disrupting bacterial enzymes and cell membranes.
- Electrolytes (Na, K, Mg) – Prevent dehydration and support immunity during respiratory diseases.
Conclusion:
Respiratory issues in poultry can lead to increased mortality, slower growth rates, and higher treatment costs. Alternative methods, such as using natural oils, vitamins, and electrolytes, can support prevention and reduce the need for antibiotics.